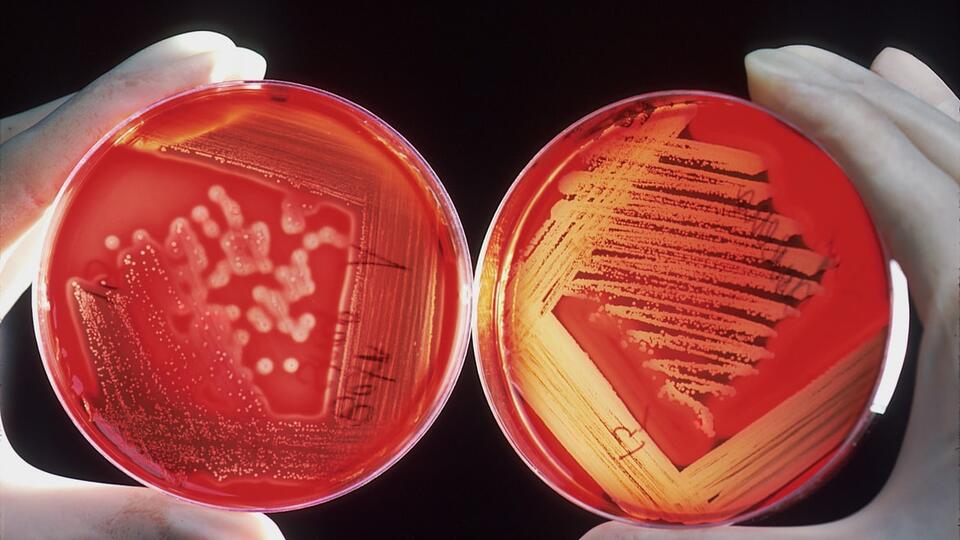

–Ш—Б—Б–ї–µ–і–Њ–≤–∞—В–µ–ї–Є –Њ—В–Ї—А—Л–ї–Є –љ–Њ–≤—Л–є —Б–њ–Њ—Б–Њ–± –±–Њ—А—М–±—Л —Б –Њ–і–љ–Є–Љ –Є–Ј –Њ—Б–љ–Њ–≤–љ—Л—Е —Д–∞–Ї—В–Њ—А–Њ–≤ —А–∞–Ј–≤–Є—В–Є—П —Б–ї–µ–њ–Њ—В—Л —Г –њ–Њ–ґ–Є–ї—Л—Е –ї—О–і–µ–є вАФ —Б—Г—Е–Њ–є —Д–Њ—А–Љ–Њ–є –≤–Њ–Ј—А–∞—Б—В–љ–Њ–є –Љ–∞–Ї—Г–ї—П—А–љ–Њ–є –і–µ–≥–µ–љ–µ—А–∞—Ж–Є–Є.
–ѓ–њ–Њ–љ—Б–Ї–∞—П –≤–∞–Ї—Ж–Є–љ–∞ –Њ—В —Б—В–∞—А–µ–љ–Є—П –њ–Њ–Ј–≤–Њ–ї–Є—В –њ—А–Њ–і–ї–µ–≤–∞—В—М –ґ–Є–Ј–љ—М
–†–∞–Ј—А–∞–±–Њ—В–∞–љ–љ–∞—П —П–њ–Њ–љ—Б–Ї–Є–Љ–Є —Г—З–µ–љ—Л–Љ–Є –≤–∞–Ї—Ж–Є–љ–∞ –Њ—В —Б—В–∞—А–µ–љ–Є—П –њ–Њ–Ј–≤–Њ–ї–Є—В –≤ –і–∞–ї—М–љ–µ–є—И–µ–Љ –њ—А–Њ–і–ї–µ–≤–∞—В—М –ґ–Є–Ј–љ—М. –Я—А–Њ—Д–µ—Б—Б–Њ—А Juntendo University (–У–Х–Ю –ѓ–њ–Њ–љ–Є—П) –Ґ–Њ—Е—А—Г –Ь–Є–љ–∞–Љ–Є–љ–Њ —А–∞—Б—Б–Ї–∞–Ј–∞–ї –†–Х–Э –Ґ–Т –Њ–± –Њ—Б–Њ–±–µ–љ–љ–Њ—Б—В—П—Е —Б–Њ–Ј–і–∞–љ–љ–Њ–≥–Њ –Є–љ–љ–Њ–≤–∞—Ж–Є–Њ–љ–љ–Њ–≥–Њ –њ—А–Њ–і—Г–Ї—В–∞.
 –§–Њ—В–Њ –Є–Ј –Њ—В–Ї—А—Л—В—Л—Е –Є—Б—В–Њ—З–љ–Є–Ї–Њ–≤ / –§–Њ—В–Њ: © unsplash
–§–Њ—В–Њ –Є–Ј –Њ—В–Ї—А—Л—В—Л—Е –Є—Б—В–Њ—З–љ–Є–Ї–Њ–≤ / –§–Њ—В–Њ: © unsplash
"–Ь—Л —А–∞–±–Њ—В–∞–µ–Љ —Б "–≤–Њ–Ј—А–∞—Б—В–љ—Л–Љ–Є" –Є —Б—В–∞—А–µ—О—Й–Є–Љ–Є –Ї–ї–µ—В–Ї–∞–Љ–Є –±–Њ–ї–µ–µ 20 –ї–µ—В. –Э–∞–Љ–Є –±—Л–ї–Њ –Њ–±–љ–∞—А—Г–ґ–µ–љ–Њ, —З—В–Њ —Н—В–Є –Ї–ї–µ—В–Ї–Є –∞–Ї—В–Є–≤–Є–Ј–Є—А—Г—О—В –∞—В–µ—А–Њ—Б–Ї–ї–µ—А–Њ–Ј –Є–ї–Є –і—А—Г–≥–Є–µ –Ј–∞–±–Њ–ї–µ–≤–∞–љ–Є—П, —Б–≤—П–Ј–∞–љ–љ—Л–µ —Б –≤–Њ–Ј—А–∞—Б—В–Њ–Љ, –Ї –њ—А–Є–Љ–µ—А—Г, –і–Є–∞–±–µ—В. –Х—Б–ї–Є —Г –љ–∞—Б –њ–Њ–ї—Г—З–Є—В—Б—П –Є–Ј–≤–ї–µ—З—М —Б—В–∞—А–µ—О—Й–Є–µ –Ї–ї–µ—В–Ї–Є –Є–Ј —В–µ–ї–∞, —В–Њ —Б–Љ–Њ–ґ–µ–Љ —Г–ї—Г—З—И–Є—В—М —Б–Є—В—Г–∞—Ж–Є—О —Б –∞—В–µ—А–Њ—Б–Ї–ї–µ—А–Њ–Ј–Њ–Љ, –і–Є–∞–±–µ—В–Њ–Љ –Є —В–∞–Ї –і–∞–ї–µ–µ", – –њ–Њ—П—Б–љ–Є–ї —Г—З–µ–љ—Л–є.
–Я–Њ –µ–≥–Њ —Б–ї–Њ–≤–∞–Љ, –і–ї—П —Н—В–Њ–≥–Њ –±—Л–ї–∞ —А–∞–Ј—А–∞–±–Њ—В–∞–љ–∞ –≤–∞–Ї—Ж–Є–љ–∞, —Б–њ–Њ—Б–Њ–±–љ–∞—П –≤—Л–≤–Њ–і–Є—В—М —Н—В–Є –Ї–ї–µ—В–Ї–Є –Є–Ј –Њ—А–≥–∞–љ–Є–Ј–Љ–∞.
"–≠—В–Њ –љ–∞—И –≥–ї–∞–≤–љ—Л–є —А–µ–Ј—Г–ї—М—В–∞—В. –Ь—Л –љ–∞—И–ї–Є –Њ—Б–Њ–±—Л–є –Љ–∞—А–Ї–µ—А, —Г–Ї–∞–Ј—Л–≤–∞—О—Й–Є–є –љ–∞ –Ї–ї–µ—В–Ї–Є —Б—В–∞—А–µ–љ–Є—П. –Ш –љ–∞—И–∞ –≤–∞–Ї—Ж–Є–љ–∞ —А–∞–±–Њ—В–∞–µ—В —В–∞–Ї–Є–Љ –Њ–±—А–∞–Ј–Њ–Љ, —З—В–Њ –Њ–љ–∞ –≤—Л—П–≤–ї—П–µ—В —Н—В–Є –Љ–∞—А–Ї–µ—А—Л –Є —Г–і–∞–ї—П–µ—В –Ї–ї–µ—В–Ї–Є —Б—В–∞—А–µ–љ–Є—П –Є–Ј –љ–∞—И–µ–≥–Њ —В–µ–ї–∞", – –њ–Њ—П—Б–љ–Є–ї –Ґ–Њ—Е—А—Г –Ь–Є–љ–∞–Љ–Є–љ–Њ.
–Ю–љ —В–∞–Ї–ґ–µ –і–Њ–±–∞–≤–Є–ї, —З—В–Њ —А–∞–Ј—А–∞–±–Њ—В–∞–љ–љ–Њ–µ —Б—А–µ–і—Б—В–≤–Њ –њ–Њ–Ј–≤–Њ–ї–Є—В –≤ –і–∞–ї—М–љ–µ–є—И–µ–Љ —Б–њ—А–∞–≤–Є—В—М—Б—П —Б —В–∞–Ї–Є–Љ–Є –Ј–∞–±–Њ–ї–µ–≤–∞–љ–Є—П–Љ–Є, —Б–≤—П–Ј–∞–љ–љ—Л–Љ–Є —Б –≤–Њ–Ј—А–∞—Б—В–Њ–Љ, –Ї–∞–Ї –і–Є–∞–±–µ—В, –∞ –Љ–Њ–ґ–µ—В –і–∞–ґ–µ –Є —Б –і–µ–Љ–µ–љ—Ж–Є–µ–є.
"–§–Є–љ–∞–ї—М–љ–∞—П —Ж–µ–ї—М –љ–∞—И–µ–≥–Њ –Є—Б—Б–ї–µ–і–Њ–≤–∞–љ–Є—П - —Н—В–Њ —З–µ–ї–Њ–≤–µ–Ї. –Ь—Л —Е–Њ—В–Є–Љ –њ—А–Є–Љ–µ–љ—П—В—М –љ–∞—И—Г —В–µ—Е–љ–Њ–ї–Њ–≥–Є—О –Ї –њ–∞—Ж–Є–µ–љ—В–∞–Љ. –Я—А–∞–≤–і–∞, –і–ї—П —Н—В–Њ–≥–Њ –µ—Й–µ –Љ–љ–Њ–≥–Њ–µ –њ—А–µ–і—Б—В–Њ–Є—В —Б–і–µ–ї–∞—В—М. –Э–∞–Љ –љ—Г–ґ–љ–Њ –±–Њ–ї—М—И–µ –±–∞–Ј—Л, —З—В–Њ–±—Л –Є—Б—Б–ї–µ–і–Њ–≤–∞—В—М –≤–∞–Ї—Ж–Є–љ—Г –љ–∞ –ї—О–і—П—Е. –Т—Б–µ-—В–∞–Ї–Є —Б–љ–∞—З–∞–ї–∞ –Љ—Л –±—Г–і–µ–Љ —В–µ—Б—В–Є—А–Њ–≤–∞—В—М –≤–∞–Ї—Ж–Є–љ—Г –љ–∞ –Њ–±–µ–Ј—М—П–љ–∞—Е. –Ш—Б—Б–ї–µ–і–Њ–≤–∞–љ–Є–µ –і–Њ–ї–ґ–љ–Њ –њ—А–Њ—Е–Њ–і–Є—В—М –њ–Њ—Б—В–µ–њ–µ–љ–љ–Њ, —И–∞–≥ –Ј–∞ —И–∞–≥–Њ–Љ –њ—А–Є–±–ї–Є–ґ–∞—П –љ–∞—Б –Ї —З–µ–ї–Њ–≤–µ–Ї—Г", – —А–∞—Б—Б–Ї–∞–Ј–∞–ї –њ—А–Њ—Д–µ—Б—Б–Њ—А.
–§–Њ—В–Њ –Є–Ј –Њ—В–Ї—А—Л—В—Л—Е –Є—Б—В–Њ—З–љ–Є–Ї–Њ–≤ / –§–Њ—В–Њ: © unsplash
–§–Њ—В–Њ –Є–Ј –Њ—В–Ї—А—Л—В—Л—Е –Є—Б—В–Њ—З–љ–Є–Ї–Њ–≤ / –§–Њ—В–Њ: © unsplash
–°–љ–∞—З–∞–ї–∞ –Є—Б—Б–ї–µ–і–Њ–≤–∞–љ–Є–µ –њ—А–Њ–≤–Њ–і–Є–ї–Њ—Б—М –љ–∞ —А–∞–Ј–љ—Л—Е –≤–Є–і–∞—Е –Љ—Л—И–µ–є, —В–∞–Ї –Ї–∞–Ї –ї—О–і–Є –Є –≥—А—Л–Ј—Г–љ—Л –њ–Њ–і–≤–µ—А–ґ–µ–љ—Л –Њ–і–Є–љ–∞–Ї–Њ–≤—Л–Љ –Ј–∞–±–Њ–ї–µ–≤–∞–љ–Є—П–Љ. –Ъ–∞–Ї –Њ–±—К—П—Б–љ–Є–ї –Ь–Є–љ–∞–Љ–Є–љ–Њ, –Ї–∞–Ї –њ—А–∞–≤–Є–ї–Њ, –Љ—Л—И–Є –ґ–Є–≤—Г—В –Њ–Ї–Њ–ї–Њ –і–≤—Г—Е —Б –њ–Њ–ї–Њ–≤–Є–љ–Њ–є –ї–µ—В.
"–Э–Њ —Б –≤–∞–Ї—Ж–Є–љ–Њ–є –Њ–љ–Є –ґ–Є–≤—Г—В –і–Њ–ї—М—И–µ. –Ы—О–і–Є –Є –Љ—Л—И–Є –њ–Њ–і–≤–µ—А–ґ–µ–љ—Л –Њ–і–Є–љ–∞–Ї–Њ–≤—Л–Љ –Ј–∞–±–Њ–ї–µ–≤–∞–љ–Є—П–Љ. –Э–Њ –≤–Њ–Њ–±—Й–µ –≤—Б–µ-—В–∞–Ї–Є –Є—Б—Б–ї–µ–і–Њ–≤–∞–љ–Є–µ –і–Њ–ї–ґ–љ–Њ –њ—А–Њ—Е–Њ–і–Є—В—М –њ–Њ—Б—В–µ–њ–µ–љ–љ–Њ: —Б–љ–∞—З–∞–ї–∞ –љ–∞ –Љ—Л—И–∞—Е, –Ј–∞—В–µ–Љ –љ–∞ –Њ–±–µ–Ј—М—П–љ–∞—Е, –∞ —Г–ґ –њ–Њ—В–Њ–Љ –љ–∞ –ї—О–і—П—Е. –°–њ–µ—И–Ї–∞ —В—Г—В –љ–µ –љ—Г–ґ–љ–∞. –Э–Њ –Љ—Л –Њ–±—П–Ј–∞—В–µ–ї—М–љ–Њ –і–Њ–є–і–µ–Љ –і–Њ –ї—О–і–µ–є", – –Ј–∞–≤–µ—А–Є–ї —Б–њ–µ—Ж–Є–∞–ї–Є—Б—В.
–Ю–љ —В–∞–Ї–ґ–µ –Њ—В–Љ–µ—В–Є–ї, —З—В–Њ –њ–Њ–Ї–∞ –Њ–±–љ–∞—А—Г–ґ–µ–љ –ї–Є—И—М –Њ–і–Є–љ –Љ–∞—А–Ї–µ—А —Б—В–∞—А–µ—О—Й–Є—Е –Ї–ї–µ—В–Њ–Ї, –Њ–і–љ–∞–Ї–Њ –Є—Е –і–Њ–ї–ґ–љ–Њ –±—Л—В—М –±–Њ–ї—М—И–µ. –Т –Є–і–µ–∞–ї–µ, –њ–Њ —Б–ї–Њ–≤–∞–Љ –њ—А–Њ—Д–µ—Б—Б–Њ—А–∞, –љ–µ–Њ–±—Е–Њ–і–Є–Љ–Њ –љ–∞–є—В–Є —Б–≤–Њ–є –Љ–∞—А–Ї–µ—А –і–ї—П –Ї–∞–ґ–і–Њ–≥–Њ –≤–Є–і–∞ –Ј–∞–±–Њ–ї–µ–≤–∞–љ–Є–є –Є –і–ї—П –Ї–∞–ґ–і–Њ–≥–Њ –Њ—В–і–µ–ї—М–љ–Њ–≥–Њ –њ–∞—Ж–Є–µ–љ—В–∞. –Ґ–∞–Ї–Є–Љ –Њ–±—А–∞–Ј–Њ–Љ, –≤ –Ї–∞–ґ–і–Њ–Љ –Њ—В–і–µ–ї—М–љ–Њ–Љ —Б–ї—Г—З–∞–µ –њ–Њ–ї—Г—З–Є—В—Б—П –≤—Л–±–Є—А–∞—В—М –љ—Г–ґ–љ—Г—О –≤–∞–Ї—Ж–Є–љ—Г. –Ю–љ –њ–Њ–і—З–µ—А–Ї–љ—Г–ї, —З—В–Њ –≤ —Н—В–Њ–Љ –Є –Ј–∞–Ї–ї—О—З–∞–µ—В—Б—П –Є–љ–љ–Њ–≤–∞—Ж–Є—П —А–∞–Ј—А–∞–±–Њ—В–Ї–Є, –Ї–Њ—В–Њ—А–∞—П –њ–Њ–Ј–≤–Њ–ї—П–µ—В —Б —Г–≤–µ—А–µ–љ–љ–Њ—Б—В—М—О —Б–Љ–Њ—В—А–µ—В—М –≤ –±—Г–і—Г—Й–µ–µ.
"–ѓ –≤–µ—А—О, —З—В–Њ –Љ—Л –Њ—З–µ–љ—М –±–ї–Є–Ј–Ї–Є –Ї –Ј–∞–њ—Г—Б–Ї—Г –≤–∞–Ї—Ж–Є–љ—Л –і–ї—П –ї—О–і–µ–є. –Э–∞–Љ –љ—Г–ґ–љ–Њ –Є–і–µ–љ—В–Є—Д–Є—Ж–Є—А–Њ–≤–∞—В—М –µ—Й–µ –љ–µ—Б–Ї–Њ–ї—М–Ї–Њ –Љ–∞—А–Ї–µ—А–Њ–≤ –і–ї—П –Ї–ї–µ—В–Њ–Ї —Б—В–∞—А–µ–љ–Є—П, –Є –Љ—Л –ї–µ–≥–Ї–Њ —Б–Њ–Ј–і–∞–і–Є–Љ –≤–∞–Ї—Ж–Є–љ—Г. –°–µ–є—З–∞—Б —Г–ґ–µ —Б—Г—Й–µ—Б—В–≤—Г–µ—В –Ї–∞–Ї –Љ–Є–љ–Є–Љ—Г–Љ –љ–µ—Б–Ї–Њ–ї—М–Ї–Њ —Б–њ–Њ—Б–Њ–±–Њ–≤ –±–Њ—А—М–±—Л —Б —А–∞–Ї–Њ–Љ –њ—А–Є –Є—Б–њ–Њ–ї—М–Ј–Њ–≤–∞–љ–Є–Є –∞–љ—В–Є—В–µ–ї... –ѓ –і—Г–Љ–∞—О, –Љ—Л –Њ—З–µ–љ—М –±–ї–Є–Ј–Ї–Є", – –њ–Њ–і—З–µ—А–Ї–љ—Г–ї –Ґ–Њ—Е—А—Г –Ь–Є–љ–∞–Љ–Є–љ–Њ.
–Ю–љ —В–∞–Ї–ґ–µ –≤—Л—А–∞–Ј–Є–ї –љ–∞–і–µ–ґ–і—Г –љ–∞ —В–Њ, —З—В–Њ —Н—В–Њ –Љ–Њ–ґ–µ—В –њ—А–Њ–Є–Ј–Њ–є—В–Є –≤ –±–ї–Є–ґ–∞–є—И–Є–µ –њ—П—В—М –ї–µ—В
–†–∞–љ–µ–µ —Б–Њ–Њ–±—Й–∞–ї–Њ—Б—М, —З—В–Њ –≤ –ѓ–њ–Њ–љ–Є–Є –±—Л–ї —Б–Њ–Ј–і–∞–љ –Є–љ–љ–Њ–≤–∞—Ж–Є–Њ–љ–љ—Л–є –њ—А–Њ–і—Г–Ї—В –љ–∞ –Њ—Б–љ–Њ–≤–µ –њ–µ–њ—В–Є–і–∞, —Б–њ–Њ—Б–Њ–±–љ—Л–є —А–∞–Ј—А—Г—И–∞—В—М —Б—В–∞—А—Л–µ –Ї–ї–µ—В–Ї–Є, –Ї–Њ—В–Њ—А—Л–µ —Б –≤–Њ–Ј—А–∞—Б—В–Њ–Љ –њ–µ—А–µ—Б—В–∞—О—В –≤–Њ—Б–њ—А–Њ–Є–Ј–≤–Њ–і–Є—В—М—Б—П –Є –љ–∞–Ї–∞–њ–ї–Є–≤–∞—В—М—Б—П –≤ –Њ—А–≥–∞–љ–Є–Ј–Љ–µ —З–µ–ї–Њ–≤–µ–Ї–∞. –Я–Њ –Љ–љ–µ–љ–Є—О —Б–њ–µ—Ж–Є–∞–ї–Є—Б—В–Њ–≤, –≤–∞–Ї—Ж–Є–љ–∞ –Љ–Њ–ґ–µ—В –њ–Њ–Љ–Њ—З—М –≤ –±–Њ—А—М–±–µ —Б —Б–∞—Е–∞—А–љ—Л–Љ –і–Є–∞–±–µ—В–Њ–Љ, –Њ–ґ–Є—А–µ–љ–Є–µ–Љ –Є–ї–Є –≤–Њ–Ј—А–∞—Б—В–љ—Л–Љ–Є –њ—А–Њ–±–ї–µ–Љ–∞–Љ–Є.
–° 1950-—Е –≥–Њ–і–Њ–≤ —З–µ–ї–Њ–≤–µ—З–µ—Б—В–≤–Њ –≤–µ–і–µ—В –њ–Њ–Є—Б–Ї–Є –≤–љ–µ–Ј–µ–Љ–љ–Њ–є –ґ–Є–Ј–љ–Є, –≤–Њ–Њ—А—Г–ґ–Є–≤—И–Є—Б—М –±–Њ–ї–µ–µ —Б–Њ–≤–µ—А—И–µ–љ–љ—Л–Љ–Є..
–Я—А–Є–Љ–µ—А–љ–Њ 56 –Љ–Є–ї–ї–Є–Њ–љ–Њ–≤ –ї–µ—В –љ–∞–Ј–∞–і –Ч–µ–Љ–ї—П –њ–µ—А–µ–ґ–Є–ї–∞ —А–µ–Ј–Ї–Њ–µ –њ–Њ–≤—Л—И–µ–љ–Є–µ —В–µ–Љ–њ–µ—А–∞—В—Г—А—Л, –Ї–Њ—В–Њ—А–Њ–µ..


